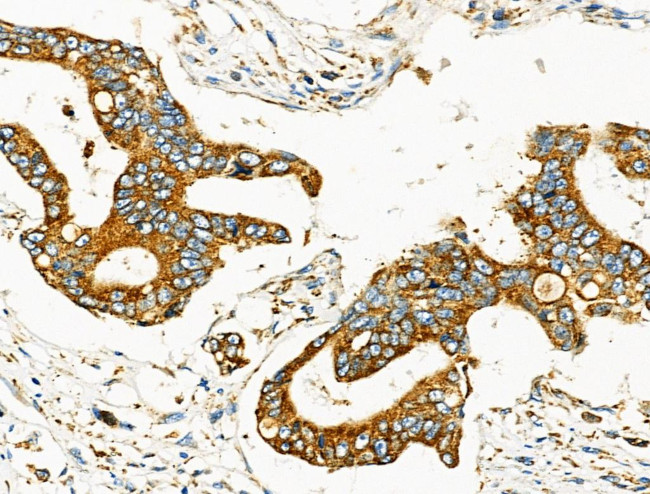
MOV10L1 Antibody in Immunohistochemistry (Paraffin) (IHC (P))

Search
Invitrogen
MOV10L1 Polyclonal Antibody
{{$productOrderCtrl.translations['antibody.pdp.commerceCard.promotion.promotions']}}
{{$productOrderCtrl.translations['antibody.pdp.commerceCard.promotion.viewpromo']}}
{{$productOrderCtrl.translations['antibody.pdp.commerceCard.promotion.promocode']}}: {{promo.promoCode}} {{promo.promoTitle}} {{promo.promoDescription}}. {{$productOrderCtrl.translations['antibody.pdp.commerceCard.promotion.learnmore']}}
图: 1 / 3
MOV10L1 Antibody (PA5-106711) in IHC (P)



Please note: We are reviewing Western blot images included in the antibody testing data in our catalog, including those provided by third parties. Unless expressly labeled or annotated as “raw-unedited”, Western blot images included in the antibody testing data in our catalog may have been edited, optimized or otherwise adjusted for presentation.
产品信息
PA5-106711
种属反应
宿主/亚型
分类
类型
抗原
偶联物
形式
浓度
规格
纯化类型
保存液
内含物
保存条件
运输条件
RRID
产品详细信息
Antibody detects endogenous levels of total MOV10L1.
靶标信息
Isoform 1: ATP-dependent RNA helicase required during spermatogenesis to repress transposable elements and prevent their mobilization, which is essential for germline integrity (PubMed:20534472, PubMed:20547853, PubMed:23166510, PubMed:25762440). Acts via the piRNA metabolic process, which mediates the repression of transposable elements during meiosis by forming complexes composed of piRNAs and Piwi proteins and governs the methylation and subsequent repression of transposons (PubMed:20534472, PubMed:20547853, PubMed:23166510, PubMed:25762440). Involved in the primary piRNA metabolic process (PubMed:20534472, PubMed:20547853, PubMed:23166510, PubMed:25762440). Specifically binds to piRNA precursors and promotes the generation of intermediate piRNA processing fragments that are subsequently loaded to Piwi proteins (PubMed:25762440). Acts via its ATP-dependent RNA helicase activity: displays 5'-3' RNA unwinding activity and probably mediates unwinding and funneling of single-stranded piRNA precursor transcripts to the endonuclease that catalyzes the first cleavage step of piRNA processing to generate piRNA intermediate fragments that are subsequently loaded to Piwi proteins (PubMed:25762440). {ECO:0000269; PubMed:20534472, ECO:0000269; PubMed:20547853, ECO:0000269; PubMed:23166510, ECO:0000269; PubMed:25762440}.; Isoform 2: May act downstream of MEF2C during heart formation. Acts as a cardiac-specific suppressor of cardiomyocyte hypertrophy and cell cycle progression, suggesting that it may suppress these processes through the regulation of CDKN1A. Such results however require additional evidence. {ECO:0000305; PubMed:11854500}.
仅用于科研。不用于诊断过程。未经明确授权不得转售。
篇参考文献 (0)
生物信息学
蛋白别名: Cardiac helicase activated by MEF2 protein; Cardiac-specific RNA helicase; Moloney leukemia virus 10-like 1; moloney leukemia virus 10-like protein 1; Moloney leukemia virus 10-like protein 1 homolog; Mov10 RISC complex RNA helicase like 1; MOV10-like protein 1; MOV10-like protein 1 homolog; Mov10l1, Moloney leukemia virus 10-like 1, homolog; putative helicase Mov10l1; RNA helicase Mov10l1
基因别名: CHAMP; Csm; Mov10l1
UniProt ID: (Mouse) Q99MV5
Entrez Gene ID: (Rat) 300141, (Mouse) 83456